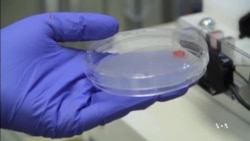
Researchers Work on 3-D Printing of Living Tissue

Three-dimensional printers are rapidly becoming everyday appliances, much like color printers a couple of decades ago. Increasingly, the technology is being used in medicine for printing bone replacements. And now, researchers in South Carolina are working on printing living tissue replacements.
Researchers at the Medical University of South Carolina have been working on fabricating living tissue, or biofabrication, since 2003.
Researcher Sarah Grace Dennis says new technology, such as the Palmetto bioprinter, advanced the process considerably.
“When I got here a year ago, we were printing just a-cellular bio-inks to see if patterns could be printed," she said. "Now we are printing skeletal muscle replica implants that we have been implanting into rats.”
Researchers prepare complex nutritious solutions, called bio-inks, made of glucose, proteins and living cells taken from the animal that will be the recipient of the new, printed tissue.
“So this would typically have at least 1.5 million cells in it,” Dennis said
The bio-inks are placed in three interchangeable dispensers of the printer’s head. Position of the printing surface and dispensing tip-ends is controlled by lasers.
Associate Chairman of Surgery for Research, Dr. Michael Yost, says the printing process is fully automated.
“And with our 3-D bio-printer, we have been able to create new microvascular networks that we can then grow new tissues in very key areas such as pancreas, liver and kidney,” he said.
Researchers point out the technique is in its early stages, but they hope in a few years they may be able to print replacement tissue for damaged human organs.
“Tissue biofabrication is a reality, and it is a reality now, and if you get to come here you get to see it," Yost said. "You will get to see it. You can not touch it, but you will see it and think this is real. And this is really human.”
But scientists warn they have to overcome large obstacles, such as how to supply the replacement tissue with the blood vessels essential for its survival.